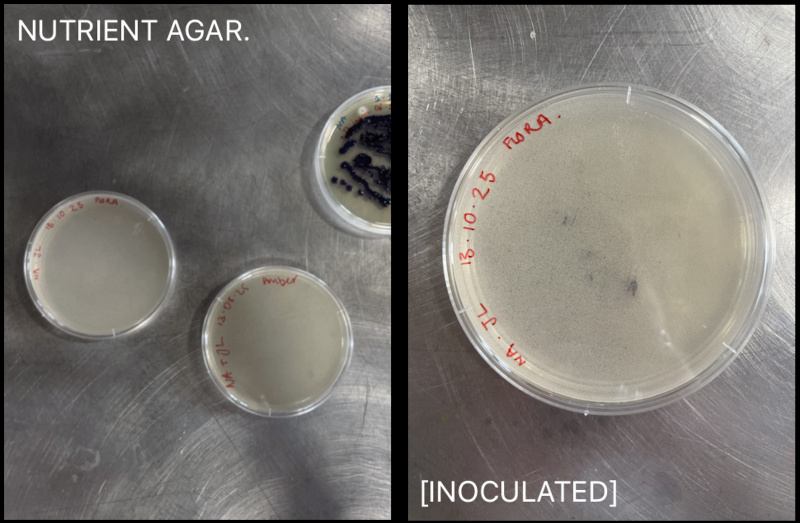

4. BioChromes¶
Research¶
- Stephanie Johnson Biochromes Archive↗
- Andy Goldsworthy’s Red Flags (my own images↗
- Natural dyes is India - Journals of Colour↗
- Harris Tweed↗
I felt so immensly inspired this week, I loved it. After watching Cecilia’s lecture I starting thinking about colours, fibres and types of flora that really resonate with me. Living in the Highlands of Scotland.. Mosses, Lichens, Mushrooms and shaggy sheep wool are some of my biggest inspirations. When researching Biochromes, I noticed this strong connection between the craftsmen, the dyes and place. For example, for centuries Harris Tweed has not only been dyed by the colours of the Outer Hebrides but it represents Scottish heritage, community livelihood, and craftsmanship for its island weavers. This has resulting in a unique visual identity that is tied to both its geographical origin and the skills passed down through generations. I find this living symbol of Scottish heritage beautiful.
Andy Goldsworthy’s Red Flags hold a similar meaning but through a totally different approach. By using red earth from each U.S. state, the fifty flags symbolize the land, its history, and the artist's hope for connection and solidarity over division, linking the earth's fundamental color to the fabric of the nation. These are additionally, reflections of the blood and iron content of the earth and our bodies, highlighting the deep connection between humans and nature.
Videos that Inspired Me¶
My Heart is in the Highlands¶
As mentioned previously, my practice has always been centred around nature and the environments I’ve encountered. My favourite flora are the mosses, lichens, ferns and heather that I find at home in Morayshire, Scotland. Their beautiful hues of green, grey, purple, blue and red alongside their unique textures and shapes, give each of them their own character. I’d love to one day make my own dyes from the colours of home and merge that with fibres from the local farmers.
I found this little gem of a book in a studio down the road from me called Naturally Useful. This book contained lots of wild colours from the local area and I found it very inspiring. Naturally Useful specialise in willow weaving, natural dying and felting. In the future I would love to work with these local practises, processes and materials to make a garment that is inside and out, made from home. The garment would be very inspired by the styles of Hedestrik and Hannah Brown through their natural fibres and colours. I am very grateful for Biochromes week as it has unlocked this idea I am very excited about and given me the knowledge to take it further with my own materials from home.
Images from home & Naturally Useful's Wild Colours book.
Biochromes¶
I made pages and pages of notes, these are just two examples of which I will refer back to throughout my practise. I wanted to take a note of Cecilia's Zero-waste chart because it was a great way of understanding the different processes and outcomes within Biochromes. As I work best visually, I made videos of our processes from throughout the week to accompany my notes. They have basic descriptions for the actions but the notes I took are below for extra reference. This will be really helpful in the future to refer to.
Our Final Biochromes.¶
- My Personal Documentation.
- Our Collective Group Documentation.
The Practical : How we got there¶
The Overall Process of Making Multiple Dyes.¶
Preparting the Fibres¶
Weigh the material [WoF] ;
150g Fabric
100g Wool
÷ 16 pieces of 10g
SCOURING COTTON FABRIC.
- Soak fabric in water
- Heat up a pot of water on the stove
- Add Sodium Carbonate to pot [mix]
- Add the material [the temperature will vary depending on the material]
- Stir occasionally
; Scour for at least 1 hour.
TRIACETATE [a Cellulose Immersion Bath]
Recipe for 500ml
- Measure 500ml Vinegar and 50g Aluminium Sulphate
- Add together and mix with immersion blender.
- Measure 25g Sodium Carbonate
- Add to water bit by bit and mix [don’t always add all the sod. Carb, if it goes white that means there is too much in there]
-
Blend. Add. Blend. Add. Until all dissolved / can’t hear it fizzing.
Now time to fix the mordant [the triacetate will be very acidic right now] -
Add 2g Percarbonate to 2L of cold water.
-
Mix mix mix until dissolved.
-
Remove the Scoured Fabric from the pot.
- Sieve and rinse in cold water.
- Dunk the fabric into the Triacetate [really work and squeeze to fully penetrate]
- Hang to dry
- Now fixate with Percarbonate i.e. dunk the fabric in [this neutralises the very acidic triacetate so it doesn’t effect the dye bath]
MORDANTING WOOL.
- Soak wool in hot water [hot allows the oxygen to get released]
- Measure Potassium Aluminium Sulphate [Alum]
; 15% of WoF = 15g of 100g of Wool.
- Heat up a pot of water on the stove
- Add the Alum and a sprinkle of Cream of Tartar [this maintains the shine]
- Stir the water and then add the wool [gently! You don’t want the wool to felt]
- Poke down and around occasionally.
; Mordant for at least 30 minutes [1 hour is good, allow the wool to cool down in the pot.]
- Leave to dry and split into even 15 chunks.
- Wet the wool again before adding to dye bath
- Submerge in dye bath and hang to dry.
The Material Measurements for the Practical :
My physical documentation of our colours.
I learnt so much throughout this practical. Almost everything was new to me so I found it all fascinating and the outcomes very rewarding. I never realised the complexity of preparing the fibres. Paying attention to their individual compounds and characteristics, I now look at textiles differently than before. Thinking deeply about where they have come from and the processes involved when working with them. Additionally I was fascinated by the potential of the colours, working with acid and alkali, minerals and mixes to manipluate their 'natural' colour. I am very proud of the huge range of colours we created and feel very honoured to have been taught by Cecelia. I can't wait to see where I can take this in the future.
Making a Lake Pigment¶
- Using Safflower
I really enjoyed this process as it made the dying process zero-waste and showed me a whole different dimension to natural dyes. As someone who loves painting and colour, I find it very inspiring now knowing I have the capabilities to make my own pigments from the materials around me. It was great to experience making both Soda and Chalk based pigments as it demonstrated the different characteristics you can get. I look forward to using this technique in the future.
Making an Indigo Dye Bath¶
The Indigo dye bath was really interesting to make as it is so different to the other dyes. As a physically living dye, I found it really interesting the different components that went into it to make it alive and dyable. For example, the indigo flower, the miso soup (not), feeding it fructose and so much more. It is such a complex yet beautiful biochrome. I particularly loved it when dyed with Weld. The vibrant green was beautiful!
Dying with Bacteria¶
- Janthinobacterium Lividum
- Place textile in petri dish [allowing space between the lid]
-
Place in autoclave.
Prepare the Food ; LUVIA BROTH
[25g per 1 litre of distilled water] -
Make a little tin foil boat and weigh 10g of LB Broth for 400ml of distilled water.
- Add a couple of drops of Glycerine [sugar for the bacteria]
- Close the bottle and shake shake shake
- Open the lid and place in autoclave.
Whilst those sterilize in autoclave...
Preparing a Nutrient Agar Petri dish & Inoculating.¶
- First sterilize the area with ethanol and the bunsen burner. Wiping ethanol on the surface around and the facing the bottle away from the flame at all times.
- Once the Agr has solidified, time to inoculate.
- Sterilize inoculation stick.
- Cool on Agar first, then swipe some bacteria onto stick
- Then transfer onto fresh Agar Petri dish.
My Inoculated Nutrient Agar Dish. Now incubate and leave to grow.
LB Broth & Inoculating Textile¶
- Having been sterilized in autoclave.
Me Inoculating my Textile.¶
[using the same process as before]
INCUBATE
2 weeks later... Ready and pressurised to kill bacteria.
-
Wash with soap and water and hang to dry.
-
Petri dishes and any contaminated materials should be sealed in a heat-resistant bag and placed into autoclave. These high temperatures effectively kill any remaining bacteria, ensuring they are no longer biologically active. (see autoclave instructions above)
FINAL OUTCOME :
[inspired by Shibori Dyeing]